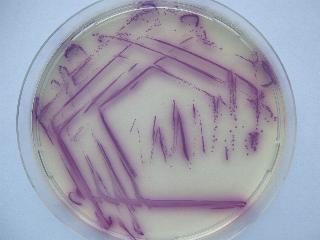
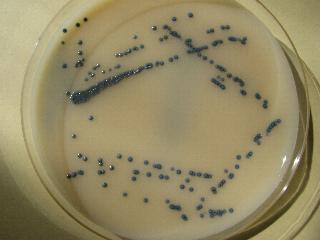
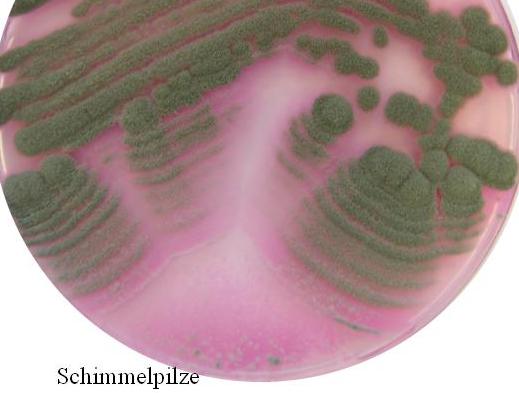
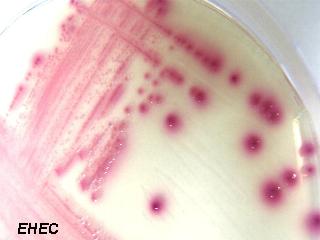
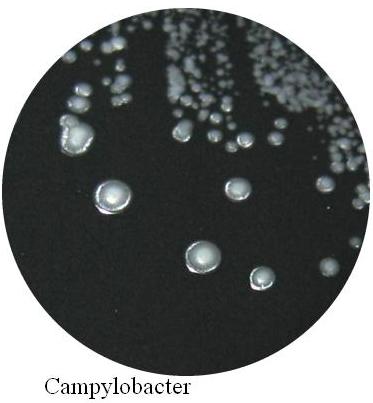
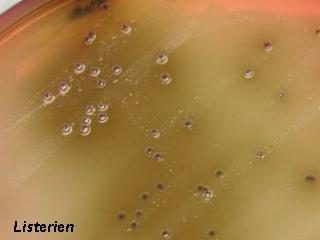

|
Auf dieser Seite gibt es einen kleinen Einblick
in die "Welt der Bakterien" |
|---|
|
nähere Infos über Salmonellen |
|---|
|
|

|
nähere Infos über Bacillus cereus |
|---|
|
nähere Infos über Schimmelpilze |
|---|
|
nähere Infos über EHEC |
|---|
|
nähere Infos über Campylobacter |
|---|
|
nähere Infos über Listerien |
|---|